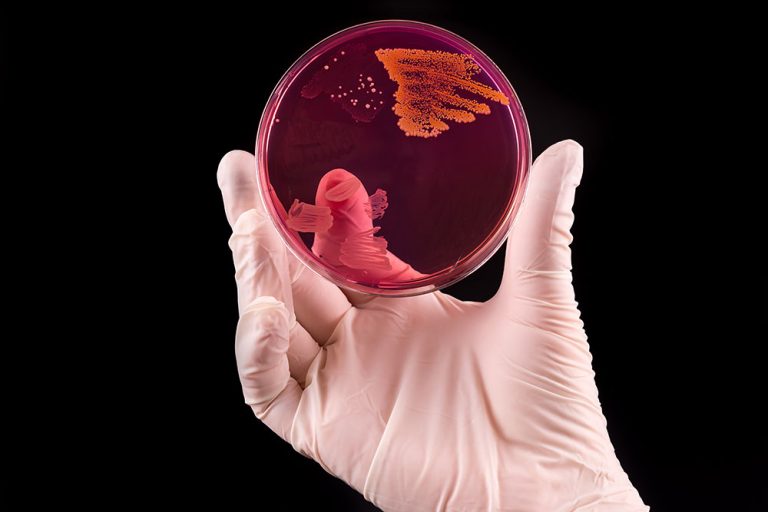

It’s like soap for your patient’s mouth: Why cyclodextrins are important for the future of oral care
During viral epidemics, dental studios face significant challenges. Amidst requirements for meticulous hygiene and virus spread prevention, cyclodextrins in oral…